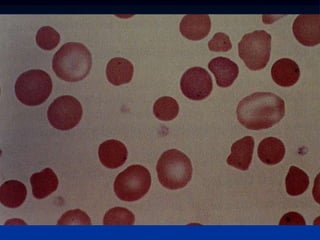
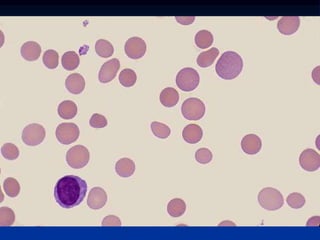

This document summarizes hereditary hemolytic anemias caused by abnormalities in the red blood cell membrane, specifically hereditary spherocytosis and elliptocytosis. It describes the pathophysiology as defects in membrane proteins like spectrin or ankyrin that cause unstable membranes. Clinical features include anemia, splenomegaly, jaundice and gallstones. Laboratory findings show microspherocytes on blood smear and increased osmotic fragility. G6PD deficiency and pyruvate kinase deficiency are also summarized as enzymatic causes of hemolytic anemia that present with hemolysis when exposed to oxidative stress or inability to generate ATP respectively.